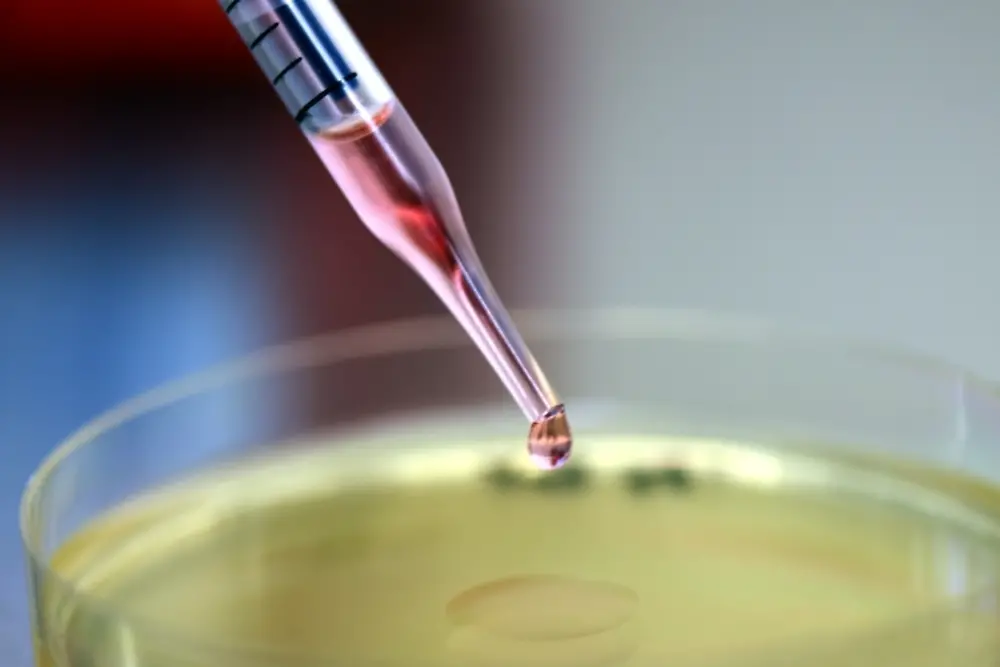
Phenion cell culture medium

- Tworzenie innowacyjnych produktów wymaga wiarygodnych metod testowania. Firma Henkel jest tego świadoma i nieustannie angażuje się w opracowywanie nowych metod testowania bezpieczeństwa składników swoich produktów – powiedział Dr Dirk Petersohn, dyrektor badań biologicznych i klinicznych w Dziale Kosmetyków Pielęgnacyjnych i Zapachowych firmy Henkel. Sztuczne biologiczne modele skóry są tworzone w oparciu o komórki ludzkiej skóry, dzięki czemu idealnie nadają się do przeprowadzania różnego rodzaju wiarygodnych analiz.
Modele skóry, które firma Henkel początkowo opracowała na własne potrzeby, są teraz wprowadzane na rynek pod marką Phenion® i udostępniane dla zainteresowanych laboratoriów oraz instytucji naukowych. Modele te stanowią alternatywny system testowania in-vitro, stosowany nie tylko w podstawowych badaniach w dziedzinie dermatologii i kosmetologii, ale też do testowania bezpieczeństwa surowców i produktów.
Aby uzyskać zgodę organów nadzorujących dopuszczenie do obrotu, test 3D Skin Comet przechodzi wszechstronny proces walidacji w pięciu europejskich i amerykańskich laboratoriach badających właściwości genotoksyczne różnych substancji. Właśnie zakończyła się z powodzeniem pierwsza faza tego procesu. Doskonałe wyniki badań to ważny krok na drodze do uznania testu 3D Skin Comet za oficjalnie akceptowaną metodę testowania – powiedział Dr Peterson. W witrynie internetowej marki Phenion® można znaleźć opracowanie z wynikami badań, a także szczegółowy protokół wykonywania testu 3D Skin Comet.
Model skóry o pełnej grubości Phenion® w teście 3D Comet Skin sprawdza się o wiele lepiej niż wcześniej stosowane metody in-vitro. Między innymi użycie komórek ludzkiej skóry w środowisku trójwymiarowym, co stanowi dobre odzwierciedlenie prawdziwej ludzkiej skóry, zapewnia większą zdolność prognozowania. Model skóry o pełnej grubości Phenion® składa się z w pełni zróżnicowanego naskórka, czyli zewnętrznej warstwy skóry, oraz skóry właściwej, która zawiera naturalną tkankę łączną z włóknami kolagenowymi. Model przypomina więc prawdziwą skórę ludzką pod wieloma względami anatomicznymi i fizjologicznymi, dzięki czemu jest idealnym narzędziem do projektów badawczych oraz do rozwijania nowatorskich alternatywnych metod testowania.